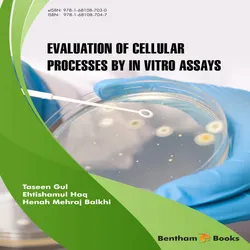

According to Wikipedia: "Noah Webster, Jr. (October 16, 1758 – May 28, 1843), was an American lexicographer, textbook pioneer, English-language spelling reformer, political writer, editor, and prolific author. He has been called the "Father of American Scholarship and Education." His blue-backed speller books taught five generations of American children how to spell and read, secularizing their education. According to Ellis (1979) he gave Americans "a secular catechism to the nation-state." Webster's name has become synonymous with "dictionary" in the United States, especially the modern Merriam-Webster dictionary that was first published in 1828 as An American Dictionary of the English Language. He was one of the Founding Fathers of the nation."
Dissertations on the English Language
Författare:
Språk:
Engelska
Format:
Evaluation of Cellular Processes by in vitro Assays
Ehtishamul Haq, Taseen Gul, Henah Mehraj Balkhi
book
Textbook of Iatrogenic Pathology
book
Android Tips for Parental Control
Elaiya Iswera Lallan
book
A Dictionary of the First or Oldest Words in the English Language : From the Semi-Saxon Period of A.D. 1250 to 1300
Herbert Coleridge
book
The King James Version of the Bible : {Illustrated & Old & New Testament}
King James
book
The Natural World of Winnie-the-Pooh
Kathryn Aalto
audiobook
Svenska värderingar? Den svenska värdegrundens dilemma
Lennart Koskinen
book
e-Pedia: Me Before You : Me Before You is a romance novel written by Jojo Moyes
Wikipedia contributors
book
Rocks : My Life In and Out of Aerosmith
Joe Perry
audiobookbook
Nya Testamentet och Psaltaren - Svenska Folkbibeln 2014
Svenska Folkbibeln
book
The Life Machines : How Taking Care of Your Mitochondria Can Transform Your Health
Daria Mochly-Rosen, Emanuel Rosen
audiobookbook
Religionernas historia - islam
Sören Wibeck
audiobook

Webster's Unabridged Dictionary (1st 100 Pages)
Noah Webster
book
English French Bible
TruthBeTold Ministry, Joern Andre Halseth, Noah Webster, Louis Segond
book
Webster's Dictionary & World English Bible
TruthBeTold Ministry, Noah Webster
book
English Hungarian Bible No3
TruthBeTold Ministry, Joern Andre Halseth, Noah Webster, Gáspár Károli
book
English Vietnamese Bible No3
TruthBeTold Ministry, Joern Andre Halseth, Noah Webster
book
Noah Webster Bible 1833
TruthBeTold Ministry, Joern Andre Halseth, Noah Webster
book
Webster's Unabridged Dictionary & Bible
TruthBeTold Ministry, Noah Webster
book
Webster's Bible 1833 - TTS
TruthBeTold Ministry, Joern Andre Halseth, Noah Webster
book
Double English Bible
TruthBeTold Ministry, Joern Andre Halseth, King James, Noah Webster
book
Webster's Unabridged Vintage Edition
Noah Webster
book
